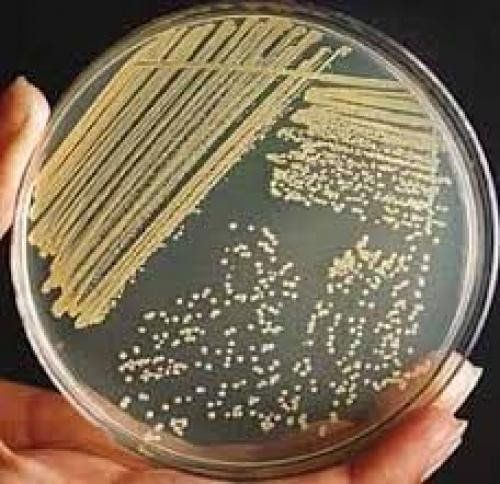
Ủ ấm đĩa thạch trong điều kiện thích hợp. Đọc kết quả sau 24h.

Bài viết được tham vấn chuyên môn cùng ThS.BS Trần Thị Vượng – Bác sĩ Vi sinh – Khoa Xét nghiệm – Bệnh viện Đa khoa Quốc tế Vinmec Hải Phòng.
Điều quan trọng trong quá trình nuôi cấy vi khuẩn là tránh không đưa thêm vi khuẩn ngoại nhiễm vào môi trường nuôi cấy. Do vậy, ngoài các thao tác luôn phải được tiến hành trong điều kiện vô trùng tuyệt đối, mọi yếu tố từ môi trường, dụng cụ chứa, dụng cụ nuôi cấy đến các vật dụng cần thiết đều phải được khử trùng trước khi sử dụng.
1. Phương pháp nuôi cấy vi khuẩn là gì?
Nuôi cấy vi khuẩn là đưa bệnh phẩm nghi ngờ chứa vi khuẩn vào môi trường thích hợp nhằm tạo điều kiện cho vi khuẩn phát triển. Tùy theo mục đích mà các môi trường nuôi cấy có các chất dinh dưỡng cơ bản hay thêm các yếu tố đặc biệt (ví dụ muối, muối mật, các chất tạo màu…) để nhận biết được các đặc tính sinh vật hóa học của vi khuẩn. Từ đó giúp nhận định sơ bộ ban đầu về nhóm vi khuẩn hoặc vi khuẩn nghi ngờ gây bệnh.
Có nhiều kỹ thuật nuôi cấy vi khuẩn, tuy nhiên có thể phân loại như sau:
Cấy phân vùng:
- Cấy định danh: cấy trên các môi trường định danh, nhằm phát hiện các tính chất sinh vật hóa học của vi khuẩn. Mỗi vi khuẩn có 1 bộ tính chất sinh vật hóa học riêng. Vì vậy sau khi cấy định danh 24h, dựa vào bộ tính chất sinh vật hóa học để xác định tên vi khuẩn.
- Cấy tăng sinh: tăng sinh số lượng vi khuẩn trong mẫu bệnh phẩm, đặc biệt với các bệnh phẩm ban đầu ít vi khuẩn như máu, dịch não tủy, dịch màng phổi…
- Cấy định lượng: nhằm xác định mật độ vi khuẩn trong mẫu bệnh phẩm ban đầu 1 cách khá tuyệt đối. Điển hình của phương pháp cấy định lượng là cấy nước tiểu.
- Cấy bán định lượng: nhằm xác định mật độ vi khuẩn trong mẫu bệnh phẩm ban đầu 1 cách tương đối. Điển hình của phương pháp cấy định lượng là cấy đờm.
- Cấy lưu chủng: cấy vi khuẩn đã định tên, đã biết tên vào môi trường thích hợp để lưu giữ chủng vi khuẩn phục vụ nghiên cứu hoặc các mục đích khác.
Môi trường nuôi cấy vi khuẩn cũng rất đa dạng. Tùy theo mục đích nuôi cấy, tùy theo loại bệnh phẩm, tùy theo căn nguyên vi khuẩn để lựa chọn môi trường nuôi cấy thích hợp. Các môi trường nuôi cấy thạch rắn như: thạch máu, thạch chocolate, thạch MacCon-key, thạch UTI phổ biến dùng với các vi khuẩn gây bệnh thường gặp. Cấy phân vùng, cấy định lượng và bán định lượng thường dùng các loại thạch này để thực hiện.
Một số thạch rắn chọn lọc cho từng nhóm, từng loại vi khuẩn như: thạch Strepto B chọn lọc Liên cầu nhóm B, thạch SS, Hektoen chọn lọc vi khuẩn salmonella, shigella…
Các vi khuẩn khó mọc, hoặc các vi khuẩn có tính chất đặc biệt thì cần các môi trường đặc biệt để ưu tiên cho vi khuẩn gây bệnh phát triển như vi khuẩn tả cần cấy trên môi trường TCBS…
Môi trường để cấy tăng sinh thường là môi trường lỏng như BHI, canh thang glucose 2%, môi trường pepton kiềm
Môi trường cấy định danh thì có thể là môi trường thạch đặc đĩa petri hoặc thạch nghiêng để tìm các tính chất sinh vatah hóa học của vi khuẩn, từ đó xác định được tên vi khuẩn.
Sau khi vi khuẩn được đưa vào các môi trường này, cần cung cấp nhiệt độ và điều kiện khí trường tốt nhất cho vi khuẩn phát triển. Hầu hết các loại vi khuẩn cần nhiệt độ 35 oC±1, khí trường bình thường là có thể phát triển. Một số vi khuẩn cần thêm CO2 trong môi trường như lậu cầu, não mô cầu …một số cần điều kiện kỵ khí. Thiết bị thường được dùng để ủ cho vi khuẩn phát triển là tủ ấm thường hoặc tủ ấm có cung cấp CO2 5%.
Trong nội dung bài viết này, xin được đề cập đến phương pháp cấy phân vùng với các vi khuẩn thường gặp

2. Cấy phân lập vi khuẩn
Phân lập là khâu quan trọng trong quá trình nuôi cấy vi khuẩn.
Mục đích của phương pháp phân lập là tách riêng các vi khuẩn từ quần thể ban đầu tạo thành các dòng vi khuẩn thuần khiết (clon) được gọi là khuẩn lạc. Khi vi khuẩn tăng trưởng và phát triển trên bề mặt môi trường rắn sẽ tạo ra những khuẩn lạc. Mỗi nhóm vi khuẩn, mỗi loại vi khuẩn có hình thái tính chất khuẩn lạc đặc trưng. Người làm xét nghiệm nhận định tính chất khuẩn lạc, sẽ lựa chọn khuẩn lạc nghi ngờ đó để định danh tên vi khuẩn gây bệnh.
Cấy phân lập vi khuẩn có thể thực hiện trực tiếp với bệnh phẩm ban đầu, hoặc thực hiện với vi khuẩn đã được cấy trên môi trường thạch rắn trước đó (trong trường hợp lần cấy phân lập ban đầu chưa tách được khuẩn lạc riêng rẽ).
Điều quan trọng cấy phân lập vi khuẩn là tránh không đưa thêm vi sinh vật ngoại nhiễm vào môi trường nuôi cấy. Do vậy, ngoài các thao tác luôn phải được tiến hành trong điều kiện vô trùng tuyệt đối, mọi yếu tố từ môi trường, dụng cụ chứa, dụng cụ nuôi cấy đến các vật dụng cần thiết đều phải được khử trùng trước khi sử dụng.

- Kỹ thuật cấy phân lập: sử dụng đĩa thạch petri để thực hiện kỹ thuật cấy phân vùng.
- Dùng que cấy vô trùng nhúng hoặc chạm vào mẫu bệnh phẩm để lấy các vi khuẩn muốn phân lập. Trường hợp cấy dịch ít vi khuẩn: dùng pipet Paster hút dịch từ ống đựng bệnh phẩm, rồi nhỏ 1-2 giọt bệnh phẩm xuống đĩa thạch petri.
- Ria que cấy vừa chạm vào bệnh phẩm thành đường zich zac trên đĩa petri có chứa môi trường thạch thích hợp. Sau mỗi đường ria liên tục, hãy đốt khử trùng que cấy và làm nguội trước khi thực hiện thao tác tiếp theo.
- Lật ngược đĩa và ủ ở nhiệt độ, thời gian thích hợp trong tủ ấm.
- Như vậy mật độ vi khuẩn sẽ giảm dần từ vùng 1 đến vùng 3. Trường hợp bệnh phẩm nhiều vi khuẩn, đến vùng 3 sẽ phân lập được vi khuẩn riêng rẽ. Mỗi vi khuẩn riêng rẽ sẽ mọc thành khuẩn lạc riêng rẽ.
Các mẫu dịch, mủ ở vị trí vô trùng nếu mọc thường mọc 1 loại vi khuẩn, 1 loại khuẩn lạc. Người làm xét nghiệm sẽ nhận định tính chất khuẩn lạc để lựa chọn môi trường cấy định danh ra tên vi khuẩn. Trường hợp không mọc sẽ trả âm tính sau 48h.
Các mẫu bệnh phẩm ở vị trí có sự hiện diện của vi khuẩn thường trú như mũi, họng, tỵ hầu, phân, đờm thì sẽ mọc nhiều loại khuẩn lạc khác nhau. Người làm xét nghiệm sẽ lựa chọ khuẩn lạc nghi ngờ để định danh.
Tóm lại, cấy phân vùng là khâu đầu tiên và rất quan trọng trong quá trình nuôi cấy vi khuẩn. Kỹ thuật và kinh nghiệm của người làm xét nghiệm cũng đóng vai trò quan trọng trong việc đưa ra kết quả nuôi cấy vi khuẩn 1 cách chính xác.
Ngoài ra để kết quả đảm bảo chính xác và kịp thời thì việc lấy bệnh phẩm đóng vài trò tiên quyết. Lấy đúng vị trí và đúng kỹ thuật sẽ cho kết quả chính xác và kịp thời nhất!
Để đặt lịch khám tại viện, Quý khách vui lòng bấm số HOTLINE hoặc đặt lịch trực tiếp TẠI ĐÂY. Tải và đặt lịch khám tự động trên ứng dụng MyVinmec để quản lý, theo dõi lịch và đặt hẹn mọi lúc mọi nơi ngay trên ứng dụng.

